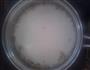
桂花奶豆腐的做法步骤5

| 食材名称 | 份量 | 热量 | 度量(每100克) | ||
| 豆浆 | 克 | 48千卡 | 16千卡 | ||
| 总量 | 300克 | 桂花奶豆腐热量/卡路里48千卡 | |||

1、原料

2、将琼脂放入水中发泡

3、将牛奶与豆浆混合

4、倒入锅中
5、加入琼脂,中火熬制

6、加入少许桂花(要好看也可以不加)

7、至琼脂全部化完,关火

8、倒入磨具中冷却

9、锅洗干净后加入100g清水

10、煮沸后加入桂花和糖,熬至糖化完。关火

11、倒入小碗中

12、摆盘加入桂花水
豆浆的热量16千卡(每100克);有利含量:低胆固醇,低钠盐,低饱和脂肪酸,富含钾;具有滋阴润燥、化痰、利大肠等功效;可与莲子、花生、胡萝卜搭配;与蜂蜜、鸡蛋、红糖相克,同食可能会引起不适;
© Copyright 2011 益优网 All rights reserved 版权所有
桂ICP备2020006802号-1